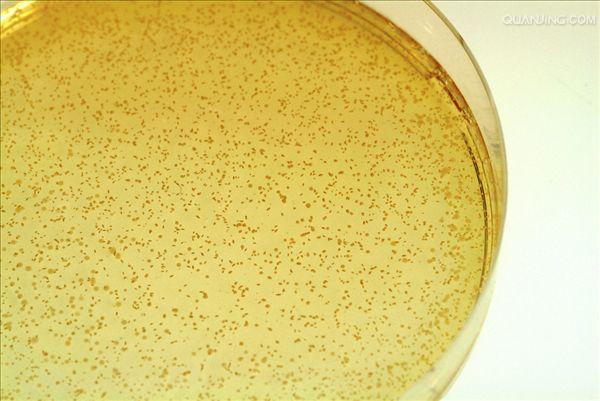
p>乳酸菌(lactic acid bacteria,lab)是一类能利用可发酵碳水化合物

乳酸菌形态图

乳酸菌微观形态图片!
图片尺寸300x297
乳酸菌
图片尺寸250x250
细菌乳酸菌革兰氏阳性棒状乳酸菌.
图片尺寸700x467
交流乳酸菌涂平板后菌落有大有小有的凸起有的不凸起是怎么回事儿
图片尺寸595x793
嗜酸乳杆菌的菌落形态好奇怪
图片尺寸800x599
发酵糖类主要产物为乳酸的一类无芽孢,革兰氏染色阳性细菌的总称,形态
图片尺寸410x300
p>乳酸菌(lactic acid bacteria,lab)是一类能利用可发酵碳水化合物
图片尺寸400x402
乳酸菌
图片尺寸640x484
最佳价格有机乳酸菌 paracasei
图片尺寸518x402
9%形态特征:淡黄色,圆形,边缘完整,表面光滑,革兰氏阴性.
图片尺寸1280x1280
乳酸君益生菌乳酸菌照片
图片尺寸450x300
乳酸菌培养菌落形态
图片尺寸900x675
乳酸杆菌(其他生物相关)_技点百科_技点网(其他生物相关)
图片尺寸769x993
一株德氏乳杆菌保加利亚亚种mga176 及其用途制造技术
图片尺寸555x564
乳酸菌在电子显微镜下形态乳酸菌可抑制有害菌生长.
图片尺寸800x533
鼠李糖乳杆菌m9上天前(左)后(右)菌落形态变化(来源:航天生物)
图片尺寸374x349
乳酸菌——您的饲料中添加了吗?
图片尺寸700x525
p>乳酸菌(lactic acid bacteria,lab)是一类能利用可发酵碳水化合物
图片尺寸600x401
双歧杆菌计数
图片尺寸800x599
生物揭秘科学探究系列之观察乳酸菌
图片尺寸640x475